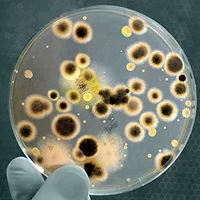

Mérieux NutriSciences Provides Microbial Identification Through Maldi-TOF Technology

Mérieux NutriSciences has recently made a new service available for the identification of bacteria based on Maldi-TOF technology. The precise identification of microbial genus and species is crucial to characterize the microbial ecology and monitor potential contaminations. Due to the extensive diversity of the microbial world, state-of-the-art techniques are necessary to identify all the species. In addition to RNA 16S or D2LSU partial sequencing of microorganisms, Mérieux NutriSciences has validated the Maldi-TOF method and enriches its database.
This “Matrix Assisted Laser Desorption Ionization-Time Of Flight” (Maldi-TOF) technique allows identifying microorganisms in a few hours after laser exposition by measuring highly abundant proteins found in microorganisms. The characteristic patterns of these highly abundant proteins are used to reliably and accurately identify a particular microorganism by matching the respective pattern with Mérieux NutriSciences’ extensive open database to determine the identity of the microorganism down to the species level.
Philippe Sans, Mérieux NutriSciences’ Chief Executive Officer, says: “Microorganism identification by Maldi-TOF represents a highly accurate, robust and fast prototypic approach. Implementing this new method allows us to provide results in a shorter time to our clients with an excellent level of quality of the results.”
Christophe Dufour, Scientific Director Microbiology Europe said: “As part of our “Big Data” strategy, our database is already very complete and we keep striving to improve it to cover as many microorganisms as possible to satisfy our clients.”
The method is available and will be ISO 17025 accredited soon.
MerieuxNutriSciences.com
Sign up for Food Safety Magazine’s bi-weekly emails!
Looking for quick answers on food safety topics?
Try Ask FSM, our new smart AI search tool.
Ask FSM →